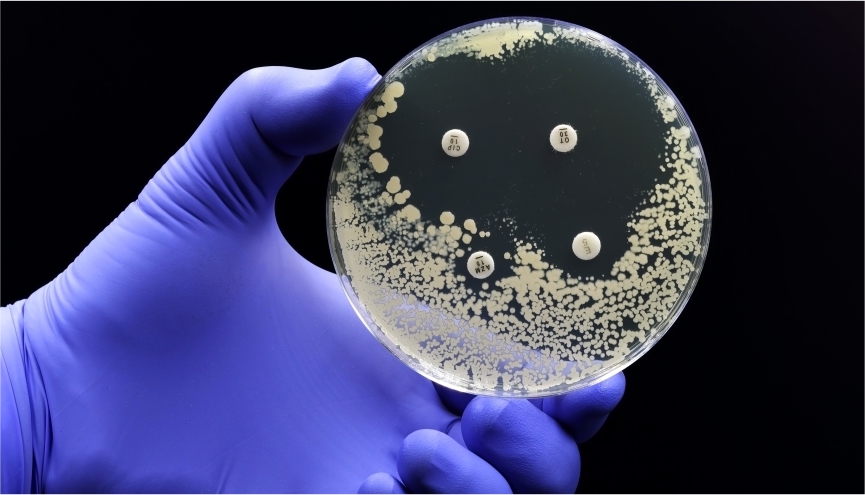

PHARMACY CORNER
Caregivers – the unsung heroes in our lives

By Stephanie Simons,
Head Pharmacist,
Lindo’s Pharmacy in Devonshire
June 9-15 is Carers’ Week in the UK. June 16 is, of course, our own Heroes’ Day – and the proximity made me think about those unsung heroes in our lives. The carers (or caregivers).
Britain’s National Health Service (NHS) describes a carer as ‘anyone – including children – who looks after a family member, partner or friend who needs help because of illness, frailty, disability, a mental health problem or an addiction’. Crucially, these carers are unpaid. And, interestingly, most of them don’t even recognise the fact that they ARE carers…until they’ve been doing the job for two years, according to the NHS. Before that, it’s just lending a hand.
We all know someone who qualifies as a carer, based on these criteria. Maybe we are a carer ourselves.
It’s a tricky job and can also sometimes feel like a thankless one – we are not getting paid, after all. And while our reward may be in heaven, even the most generous soul likes to get a bit of praise here on earth.
The NHS points out that carers’ roles are sometimes made even more difficult by the very closeness (and complexity) of their relationship with the person they are looking after. Your mother. Your child. Your husband. It’s complicated, as they say.
So, this month, let us celebrate these community heroes. Heroes who don’t get medals, but without whom we would struggle. What can we do to make their lives a tiny bit easier? Well, here at pharmacy corner we stock a wide range of products for those folks you may be caring for – things like disposable incontinence pants, for men and women (by Depend, Poise and the Honey Pot company…available on dropit.bm, too). Or barrier cream – over the counter items (like Sudocrem or Desitin) – to help with the beginnings of pressure sores. If you are worried about a potential bed sore, though, make sure to talk to one of our pharmacists – or your GP.
How about dry shampoo Batiste and Garnier Fructis are two brands that we carry – for those in-between-showers days, when a bit of freshening up is called for. We also have massage oil, if lack of movement is an issue and a physiotherapist thinks this will help. Plus, standard staples like cotton buds and pads.
And what about the carers themselves? Sometimes, in order to carry on being one of life’s helpers, you need to take time out to help yourself. We have pain relief for back issues – no matter how strong you are, helping your special person in and out of bed or their favourite chair can take its toll. Clearly, if you have serious back issues, speak to your doctor. But if it’s a twinge, we stock a great selection of NSAIDs (non-steroidal anti-inflammatories) that can help: in pill form (Advil and Aleve, to name just two), and also gels or rubs like Aspercreme, Salonpas and Voltarol. Prolonged use of these tablets can cause stomach or kidney issues, so if your backache persists, speak to your doctor. But for the occasional ache and pain, we are a great first port of call.
And for some old-fashioned pampering, after a long and possibly fraught day, what about a fragrant bath soak? We have some delicious products from Aura Cacia, Dr. Bronner’s and EO. How about a relaxing lavender foaming bath in the evening? Or if baths are not your thing, then an aromatherapy shower tablet? Assuming you have a bit of water pressure, then pop it in the shower, where the water spray will hit it, inhale, and wash away the cares of the day. Bliss.
Stephanie Simons is the head pharmacist at Lindo’s Pharmacy in Devonshire. She earned her Bachelor of Science in Pharmacy at Massachusetts College of Pharmacy and has been practicing for over 20 years. She is a registered pharmacist with the Bermuda Pharmacy Council and is a member of the Bermuda Pharmaceutical Association.
Put your best foot forward…

Athlete’s foot is a common skin infection of the feet caused by a fungus. It causes itchy white patches and cracked skin, usually between the toes.

By Stephanie Simons,
Head Pharmacist,
Lindo’s Pharmacy in Devonshire
As any self-respecting Bermudian can tell you, May 24 marks the true start of summer. Time to get ready for the water – be that the beach or the boat. Which means…exposing your feet. Gulp.
As James Brown once sang, you got to get on the good foot. But, honestly? Many of us have feet that we would rather keep hidden. Not so much the good foot as the bad foot. Fear not, though. There is still time to treat your tootsies, before you have to bare them in public. And no matter what the problem, if ‘this little piggy’ goes to our Pharmacy corner, help may be at hand…
GOODBYE FUNGUS, HELLO FUN…
Small wonder that our feet are perfect targets for fungal infections. For one thing, each one contains approximately 250,000 sweat glands. That’s a lot of sweat. Then, we keep them swaddled in socks and shoes. And even when they’re liberated, they’re often exposed to places (changing rooms, school or public showers) which are hotbeds of fungus. Result: trouble.
Take athlete’s foot. Despite the name, this is an equal opportunity pain in the extremity, affecting couch potatoes as well as jocks. It usually starts between the toes – fungal infections love moist, warm conditions – but can then spread, causing itching, flaking and discolouration.
An antifungal medication called ‘Terbinafine’, sometimes known by the brand name Lamisil, has been shown to be effective in combating this unwelcome development.
Talk to one of our pharmacists about the best treatment for you. Anti-fungal medications come in many forms – creams, gels, sprays and powders. And we stock a wide range, from brand leaders like Canesten, Lamisil and Daktarin.
Sadly, it’s not just the skin on your feet that fungus tackles. It can attack the toenails, too: turning them yellow, sometimes thickening them; or causing them to chip. Luckily, nail fungus can also usually be cleared up with over-the-counter products like medicated varnish or creams.
Again, flag down one of our pharmacists for advice. Be warned that nail and skin fungus infections can take a while to disappear (weeks to months or longer). So, persevere – and if at first you don’t succeed, talk to your doctor. They may suggest upping the ante and using an oral medication.
HELP FOR HEELS
Sometimes it’s not moist clammy feet that are the problem, but the opposite. The skin on the bottom of our feet is thicker than anywhere else on our bodies – because there is an extra layer of epidermis (the Stratum Lucidum) which helps to protect our long-suffering soles from friction and retain moisture. But for a number of reasons – ill-fitting shoes, prolonged periods of standing, or even just getting older (our heels tend to become less padded over time) – the skin there can become dry and eventually start to crack and split. Which is not a good look – and also hurts like the dickens. We have some solutions for this, too. A wide range of heel balms: super moisturising and softening products which you can massage in at night (and then leave to work, under cover of a pair of bed socks). Flexitol, Dr. Scholl’s and Eucerin all offer treatments which will leave your feet softer, and ready for a barefoot summer stroll along a sandy pink beach.
PREVENTION IS BETTER THAN CURE
Outside of summer sandal season, it’s often a case of ‘out of sight, out of mind’ with our feet. Which means we can be in for a shock when it’s time to peel off. Why not pay a bit more attention to them, given how important they are to us? Take time to give them some TLC…all year round.
A foot file, used after you’ve soaked your weary dogs in warm water – or after a shower or a bath – can work wonders, leaving your feet feeling and looking beautifully buffed. We have a selection in store. Check them out.
We also stock other items to help you put the final touches to your tootsies: nail clippers, files and emery boards. And wax – in case you are one of the lucky people who have hair on their feet (it’s not just for hobbits). The good news is that hairy feet usually means you have good circulation. Silver lining!
And now, time to put your best foot forward…
Stephanie Simons is the head pharmacist at Lindo’s Pharmacy in Devonshire. She earned her Bachelor of Science in Pharmacy at Massachusetts College of Pharmacy and has been practicing for over 20 years. She is a registered pharmacist with the Bermuda Pharmacy Council and is a member of the Bermuda Pharmaceutical Association.
Pharmacy Shame
By Stephanie Simons,
Head Pharmacist,
Lindo’s Pharmacy in Devonshire
PHARMACY SHAME: The feeling of shame which comes over you when you are spotted by someone you know (a friend, a neighbour, or heaven help you, your boss) popping something embarrassing into your trolley.
We’ve all felt it. Because while there are lots of fun things in our little corner of Lindo’s, there are also items which nobody would describe as fun. But which are, nonetheless, vital to keeping our lives on track.
Let’s look at some of the top entries in the Hall of Shame…
If you’ve ever sidled into this aisle looking furtive, then stop and stand tall. When you think about it, at any moment many – MANY – other people in the shop will be wearing pads of some sort or another. Diapers, sanitary pads, incontinence protection. Where would we be without these things? Stuck at home for most of the time, that’s where.
Think of these items as liberating, not shaming.
We have a great range of products, whatever your needs. Check it out next time you’re in the store. Proudly!
NUTS TO NITS
Kids and head lice. They go together like love and marriage, or a horse and carriage, while not being nearly so nice as any of the above.
Head lice, or nits, are transmitted most easily by head-to-head contact – and children are always putting their heads together, literally. Bless them.
Remember: if your child has head lice, it’s not a sign that you are a slovenly parent. It’s a sign that you are a parent, full stop. Nits happen. So don’t panic. We have lots of different treatments, including Tea Tree Shampoo (Healthaid is a good brand) or a few drops of Tea Tree oil in your favourite shampoo, to deal with the problem. And our team will be happy to guide you towards the right solution for you and your child.
Many people find that teasing a fine-toothed comb through hair after shampooing and conditioning (lice dislike the smell of coconut, apparently, so that’s a good option) works well. This technique is gentle on your babies’ hair, does not involve chemicals (or strong smells). And helps keep track of your progress – body count – in the battle against the little blighters.
THE BOTTOM LINE
It’s a fact of life that pharmacy shame is often associated with our nether regions. You can get haemorrhoids, or piles, for any number of reasons, including pregnancy, being overweight, getting older (and losing muscle tone), or having a bad bout of diarrhoea – as in, Norovirus. Maybe there’s not enough fibre in your diet. As you can see, it’s a pretty big group.
We stock medicated wipes and creams to shrink haemorrhoids and ease your pain, including Anusol and Preparation H – though if the problem persists you should really speak to your doctor.
And if your troubles are related to a lack of fibre, you may find that using a gentle supplement – like Metamucil, or Miralax – can help.
Ask our helpful pharmacists for advice – and if you’re too embarrassed to do it face to face, you can always ring us we’ll be more than happy to answer your questions.
WARTS AND ALL
Plantar Warts – sometimes called Verrucas – are no fun. They pop up on the bottom of your foot, are round, sensitive to touch – and have a little black dot in the middle. Like an evil eye. They are caused by the human papilloma virus (HPV), which can be picked up more easily if your feet are wet.
In children, they will usually go away fairly quickly on their own. But when passed on to other, older members of the family, whose immune systems are not quite so sporty, help may be required. We’ve got a number of products, from field leaders Scholl and Compound W, which can tackle the problem, while easing the pain.
Remember, some of these items can be ordered on dropit.bm, if you can’t get to the pharmacy.
Stephanie Simons is the head pharmacist at Lindo’s Pharmacy in Devonshire. She earned her Bachelor of Science in Pharmacy at Massachusetts College of Pharmacy and has been practicing for over 20 years. She is a registered pharmacist with the Bermuda Pharmacy Council and is a member of the Bermuda Pharmaceutical Association.
The History of Vitamins

By Stephanie Simons,
Head Pharmacist,
Lindo’s Pharmacy in Devonshire
I’m sure we’ve all been encouraged (or ordered) at some point in our lives to: ‘Take your vitamins!’ And we’ve probably told our own children the same thing. Not to boast, but you may have noticed that we have a pretty impressive range of supplements in our pharmacy corner.
But what, exactly, do we know about these essential nutrients?
THEY’RE NEWER THAN YOU THINK…
The first vitamin pills first started popping up on pharmacy shelves from around 1916. One of the leading brands was Mastin’s Yeast Vitamon Tablets – which contained vitamins A, B, C, Calcium, Iron and ‘Nux Vomica’. Which sounds kind of scary – and was. A homeopathic remedy for heartburn, it was made from the seeds of the strychnine tree. Yes, that strychnine.
THE VITAMIN STAKES…
There were plenty of scientists who might claim to have discovered vitamins: a Japanese professor of agricultural chemistry called Umetaro Suzuki; an Englishman called Sir Frederick Gowland Hopkins and a Dutch doctor called Christiaan Eijkman.
But the ‘father’ of the vitamin is generally considered to be a Polish biochemist called Kazimierz Funk, who was born in Warsaw in 1884. Maybe because, in 1912, he came up with the name.
The son of two doctors – and Jewish (which helps to explain why he wound up relocating permanently to America in the 1940s) – he had hip dysplasia as a child. But there was nothing wrong with his brain: he set off for university in Switzerland at 16 and graduated with a PhD in organic chemistry at 20.
CHICKEN AND RICE…
In the early 1900s, Funk became fascinated by the work of Christiaan Eijkman.
The Dutchman, who was 26 years older than Funk, had been trying to find the ‘toxin’ responsible for beriberi – a common disease at the time which caused nerve damage and heart failure.
He did experiments on chickens, exposing them to the disease (don’t ask how) and sure enough, they all died. But when he got a new batch, and changed their diet, a strange thing happened. The chickens that ate white rice died. Again. But the ones that ate brown rice did not. And when some sick birds were given brown rice, they got better.
FUNK FOLLOWS THE TRAIL…
Picking up the beriberi baton, Funk did his own experiments – this time on pigeons. With the same results.
But unlike Eijkman (who remained fixated on the toxin theory), Funk began to think that beriberi was a ‘deficiency disease’. Something in the brown rice was protecting the birds; and its absence was making them sick.
In 1912, in a lab in London, Funk (who by this time had anglicised his name to ‘Casimir) found that something. He called it a ‘vitamine’: a mash-up of ‘vital’ and ‘amine’ (the name of a compound containing nitrogen).
Funk believed his ‘vitamine’ was B1 (thiamine). Turns out it was actually B3 (niacin). Which doesn’t cure beriberi. And isn’t an amine. But never mind: vitamin research was underway. And when it became obvious that not all vitamines were ‘amines’, that final ‘e’ was quietly dropped and they became plain old vitamins.
THE GANG’S ALL HERE… 
By 1948, the last of the ‘essential’ vitamins had been discovered. There are 13 in all: A, C, D, E and K – plus eight B vitamins. They were named roughly in order of discovery (though some of the Bs came limping in later, with B12 bringing up the rear).
Vitamin K is out of step because when scientists realised it was involved in blood clotting, they gave it the German name for coagulation (‘koagulation’). Which is lucky, since vitamin C was already taken.
VITAMANIA…
By the early 1940s, vitamins and supplements were not just on the scene – they were becoming household staples. Magazines like Good Housekeeping were promoting them. Advertisers extolled their powers (‘sunshine in a bottle!’) – and even President Franklin Delano Roosevelt got on the bandwagon. Concerned about the weediness of many GIs enlisting for service in the war in Europe, he encouraged awareness of the benefits of a balanced diet, including vitamins. Like most fads, it went too far – and in 1942 the term Vitamania was coined to describe the fashion for relying on pills and potions rather than good food, to stay healthy.
YUMMY GUMMIES…
The holy grail for vitamin manufacturers was to find some way of making their pills palatable.
Chewable vitamins arrived in the late 1960s – most popularly in the form of the Flintstones multivitamins. They looked cute but still tasted a bit meh.
The first gummy vitamins – Yummi Bears – were invented in 1997. Inspired by the Haribo Gummy Bears (created by German confectioners in Bonn in 1922), they were initially made with gelatine. But because that uses pig skin, the recipe was later tweaked – for ethical and dietary reasons – to use pectin instead.
Gummies were a game changer – so much so that today, they are the main way that Americans aged 35 and under get the vitamins, minerals and supplements they require. So, take your vitamins. And be glad your recommended daily allowance does not include Nux Vomica.
Stephanie Simons is the head pharmacist at Lindo’s Pharmacy in Devonshire. She earned her Bachelor of Science in Pharmacy at Massachusetts College of Pharmacy and has been practicing for over 20 years. She is a registered pharmacist with the Bermuda Pharmacy Council and is a member of the Bermuda Pharmaceutical Association.
The Heart of the Matter

By Stephanie Simons,
Head Pharmacist,
Lindo’s Pharmacy in Devonshire
Do you ever see something and think: ‘That does my heart good!’ Maybe it’s just an everyday sight – a particularly peachy sunset. Or a photo of loved ones, shared on social media. Or maybe witnessing a random act of kindness. Often, these moments occur when we stop and take the time to notice what’s going on around us. And they can make us feel irrationally but blissfully happy.
But what if we thought about it literally, rather than metaphorically? What does your heart good, in the medical sense? It seems a fitting question in February, which is international Heart Health month. And you’ll be pleased to know that there are some very easy things you can do to help your ticker…
DIET
One of the main ways to improve your heart health is to improve your diet. Are you getting enough of the good stuff? Like fish – which is full of Omega-3 oil. Medical experts recommend two helpings of fish a week. Preferably oily ones (like tuna, mackerel or sardines). We stock fresh fish in our supermarket – but tinned is good, too.
We also stock Omega 3 supplements – in case fish is not your dish – but talk to one of our helpful pharmacists about whether they are suitable for you. Some folks (those allergic to shellfish, for instance, and pregnant women) should not be taking them. There are also plant-based Omega-3 products as alternatives.
Nuts are also a great source of good fats and fibre – and hence a perfect heart healthy snack. But remember to keep those portions small. Just a handful. And avoid salty processed nuts (dry roasted, honey roasted). Plain roasted ones are best.
Finally – don’t faint – but dark chocolate could be your heart’s friend. Not just any old chocolate. It’s got to be at least 70 per cent cocoa content; and not full of sugar or other heart unhealthy bits (toffee!). Again, you’ll have to exercise some restraint. Doctors recommend 1-2 ounces a day. A morsel, not a mountain.
EXERCISE
Regular, gentle exercise is good for your heart, whatever your age. Nobody is saying you have to take up jogging at 92, but why not try to incorporate a bit more exercise into your daily routine? Take the stairs at the office, instead of the elevator. If it’s safe to do so (as in, there is a sidewalk or verge) get off the bus one stop earlier and walk a little bit further. Or take the first parking space you see, rather than aiming for the one right outside the door. Not only will you do your heart a favour; you may also see things you miss, when you’re stuck in traffic. Things that will lift your heart!
STOP SMOKING
We’ve been here before. If you don’t know by now that smoking is bad for just about every bit of your body, you’ve really not been paying attention.
But clearly the problem is that for most smokers, it’s not a lifestyle choice, but an addiction.
If you want to stop – and have tried and failed before – talk to your GP about how you can wean yourself off the habit. Or talk to one of our pharmacists. We stock a number of products that can help you in your fight.
LIMIT YOUR DRINKING
We have just escaped the clutches of Dry January. And unless you are planning to follow that with giving up alcohol for Lent – a rare double – you’ll no doubt be raising a glass to getting back to ‘normal’.
But like smoking, we all know that even ‘normal’ moderate drinking is not great for our health.
If you are determined to drink, why not think about replacing that Dark & Stormy, or bottle of beer, with a medium glass of red wine?
Studies have shown that in controlled amounts, red wine can help to lower sugar levels in your blood, and reduce cholesterol, too. Both good developments for your heart. There are conditions, though. Having a glass of red wine with a meal is better for you than having one on its own. Just saying.
LOOK AFTER YOUR TEETH!
Weird as it sounds, good oral care can also help your heart stay healthy. Many medical studies have shown that people with poor oral health – gum disease, for instance – have much higher rates of cardiovascular disease. Doctors are still trying to figure out why this might be. One theory is that bacteria from your mouth can travel through the bloodstream to your heart, and cause issues there. Whatever the reason, though, it makes sense to look after your teeth and gums. Make sure you like your toothbrush! We’ve got a large selection to choose from. Ditto your toothpaste. And don’t forget the dental floss – a major weapon in the fight against gum disease.
BE MORE CHILL
Yes, it’s an annoying expression, but the idea is a good one. Keeping stress levels low is a good way to look after your ticker, because stress – as the name suggests – puts strain on your heart. There are some easy ways to do this. Yoga, or mindfulness, is one. But if that’s a bit hippy dippy for you, what about a walk? Some bits of Bermuda are not designed for walking – and you don’t want to help your heart and wind up in ER after being clipped by a car. But we do have some lovely parks and nature reserves where you could spend a happy (and healthy) 20 minutes stretching your legs and enjoying some ‘That does my heart good!’ moments.
Stephanie Simons is the head pharmacist at Lindo’s Pharmacy in Devonshire. She earned her Bachelor of Science in Pharmacy at Massachusetts College of Pharmacy and has been practicing for over 20 years. She is a registered pharmacist with the Bermuda Pharmacy Council and is a member of the Bermuda Pharmaceutical Association.
Conquering those Bad Habits

By Stephanie Simons,
Head Pharmacist,
Lindo’s Pharmacy in Devonshire
At this time of year, it often feels like we are being bombarded by ‘New Year – New You!’ messages. Dry January, Veganuary…where will it all end? Sadly, for most of us, it will end in…February. If not before.
Sometimes our resolutions are so ambitious they are doomed to fail. But it’s also true that (as Sheryl Crow almost sang) a change could do you good. Especially if you are realistic about what you want to achieve. Start small(ish) and give the ‘New You’ a better chance of survival…
NAIL THAT BAD HABIT
Are you still biting your nails? Don’t hang your head – nail biting is not just for kids. It’s something many of us do when we are stressed or depressed. But there are a couple of good reasons to stop – and not just the obvious one (that it’d be nice to have hands you could show off, rather than hide).
First, repeated nibbling can lead to nails growing back in a wonky fashion. Second, prolonged biting can actually damage another bit of your body – your teeth.
We stock a helpful – disgustingly bitter – nail varnish called Stop ‘N Grow, which once tasted, will put you off making that same mistake again.
If you’ve been worrying your nails for a while, they may be in bad shape. Slicking on a coat of nail strengthening polish (from Mavala, again, or Sally Hansen) will improve their appearance, and stop new growth from splitting. We stock a range of products by Nailtek that are very good. Keeping your hands (and cuticles) moisturised with hand creams by Cerave, Eucerin or Neutrogena will also help here.
Finally, keep your nails nice and short – to remove temptation (we have nail clippers and files).
Then, get ready to put those hands in the air!
SICK OF BEING SICK?
Are you tired of waking up in the morning feeling below par? Why not vow to make 2025 a healthier year all round. No need to go the full Veganuary. But getting more fruit and vegetables into your diet (check out the amazing fresh produce on display right outside our pharmacy) is a great idea when you feel like you are fraying at the seams.
And how about starting a new routine: kicking off the day with an age and lifestyle appropriate multi-vitamin. We stock a large selection from Centrum, One A Day, Nature’s Way and Vitabiotics, so whatever stage you’re at – expectant moms, senior citizens, wannabe athletes, teens – there is something for you.
Many now include a probiotic; among them the deliciously chewable Olly vitamins, which are so tasty you’ll actually look forward to taking them. Seriously!
GENTLY DOES IT
Setting an ambitious goal – like running in the May 24 Half Marathon – as you resolve to get fit in 2025 is admirable. But sometimes less is more. Particularly for those of us with joint issues, or more mileage on the clock.
So why not opt for a less terrifying target. The UK’s National Health Service recommends that we all do 150-300 minutes of ‘physical activity that raises the heart rate’ a week. That boils down to around 22-43 minutes a day. Which still sounds pretty daunting.
But physical activity that raises the heart rate could mean a walk – along the railway trail, or through Cooper’s Island Nature Reserve. Or some energetic gardening. (Both have the added stress-busting benefit of getting you out into the great outdoors.) Even better: a recent survey carried out by researchers at Cambridge University showed that doing just half that amount of exercise – as little as 11 minutes a day – can significantly reduce your chances of developing heart disease and cancer.
If you suffer from arthritis, or just aches and pains, then you may want to consider taking some gentle pain relief before, or after, your exercise. Talk to one of our pharmacists about what’s right for you. Acetaminophen – in the form of Tylenol, paracetamol or Panadol – is a good safe bet for an over-the-counter option, because there are few side effects.
You may also find that using a support bandage or brace – for your knee or ankle – helps stabilise the joint and allows you to move more freely, and with less discomfort. We stock a range from Ace and Futuro. Talk to your GP or one of our pharmacists if you’d like to know more.
THE SMOKING GUN…
So, this IS a big one… But smoking is so bad for you – a new survey by University College London estimates that men lose 17 minutes of life for every cigarette they puff…and women 22 minutes – it’s probably worth tackling.
If you really want to kick the habit, ask your doctor – or one of our pharmacists – about ways to wean yourself off the killer weed. We stock a number of Nicotine Replacement Therapies (NRTs), including patches, gum, inhalers and sprays (nasal or mouth) Nicorette and Nicotinell brands, which will give you a reduced level of nicotine without the dangerous side-effects of smoking.
Which NRT is right for you will depend on your age, body type and lifestyle. But we should be able to offer an option to suit you. So, you can stub out that cigarette habit once and for all.
Stephanie Simons is the head pharmacist at Lindo’s Pharmacy in Devonshire. She earned her Bachelor of Science in Pharmacy at Massachusetts College of Pharmacy and has been practicing for over 20 years. She is a registered pharmacist with the Bermuda Pharmacy Council and is a member of the Bermuda Pharmaceutical Association.
Stocking Stuffers in Pharmacy Corner

By Stephanie Simons,
Head Pharmacist,
Lindo’s Pharmacy in Devonshire
‘Tis the season to be on the lookout for quirky little items that can be popped into Christmas stockings. And funnily enough, your pharmacy can be a goldmine, when it comes to last-minute treats (plus, by shopping locally, you’ll be on Nice List, too).
SCENTSATIONAL GIFTS…
Essential oils are the classic good things that come in small packages – and a little goes a long way. We have a great selection, from Aura Cacia (who do actually stock the original Christmas scent, Frankincense & Myrrh), and also Now – whose offerings include cinnamon cassia oil, spearmint and cloves.
They can be used in diffusers (to make the whole house smell sweet), or even dubbed neat onto the tiles in your shower, to be activated by the steam. Never add undiluted essential oils to your bath – they won’t disperse and could burn your skin. Luckily, simply by adding a few drops to a neutral carrier oil (like jojoba or coconut) you can make your own fragrant bespoke bath oil. Ta da!
SOAP OPERA…
Looking for something (else) for the bathing beauty in your life? How about one of our Nesti Dante Bionatura soaps, made from only the finest ingredients…like argan oil and wild hay.
At the other extreme, there’s Surly Soap – for the worker in your midst. Surly’s ‘Mild’ bar is gently exfoliating, so the more you use it, the more dirt and grease you scrub off.
THE WINNER, HANDS DOWN…
Treats for the hands and nails are always welcome. Given how thoroughly we are all washing our hands these days – 20 seconds at the taps, people – who doesn’t need moisturiser? We stock handy (handbag sized) containers, from market leaders like Aveeno, Neutrogena, Cerave and Burt’s Bees, to keep your hands soft and supple. It’s also worth having a look at Nail Tek’s excellent range – like first aid for your nails! One little bottle can help transform damaged, brittle or soft nails into things of beauty. Next stop: the manicurist!
LIP BALM
Get ready to pucker up under the mistletoe with some lip salve. We’ve got some cute products from Blistex, ChapStick and Dr Bronner’s, to name just three. Choose from dinky pots, or the traditional lipstick format (in a range of flavours…like Blistex’s Fruit Smoothies, ChapStick’s Tropical Paradise trio or Dr Bronner’s orange and ginger). There are even some seasonal flavours.
CROWNING GLORIES
You don’t have to have a long-haired lover from Liverpool to appreciate that you can never have too many hair bands, or scrunchies, or barrettes in the house (assuming your house is not Warwick Camp). Check out our selection of hair accessories (from brand leaders Goody) – including soft towelling headbands in bright colours, and handbag sized brushes and combs – for the well-groomed guy or gal on your list.
GOOD FOR THE SOLE…
For the Cinderella in your life – who’s going to be cramming her feet into gorgeous (but pretty darned uncomfortable) shoes over the 12 days of Christmas, how about a pack of Scholl’s Party Feet? These gel inserts slip neatly into footwear, so instead of hobbling you’ll feel like you’re dancing on air.
YOU SCRATCH MY BACK…
In the shower, or the bath, a loofah massager can reach the parts that we mere mortals cannot. Earth Therapeutics’ all-natural back scratcher has a long handle, and comes with a loop, so you can hang it in your bath or shower. Ready to scratch that itch!
Stephanie Simons is the head pharmacist at Lindo’s Pharmacy in Devonshire. She earned her Bachelor of Science in Pharmacy at Massachusetts College of Pharmacy and has been practicing for over 20 years. She is a registered pharmacist with the Bermuda Pharmacy Council and is a member of the Bermuda Pharmaceutical Association.
Is your ‘Sick Shelf’ fit for purpose?

By Stephanie Simons,
Head Pharmacist,
Lindo’s Pharmacy in Devonshire
WINTER is coming, as some man in Game of Thrones once said. Luckily, In Bermuda, this probably won’t mean a new ice age. But it will certainly mean the return of seasonal viruses like Covid-19, the flu and our old friend, the common cold.
Now is the time to make sure that the ‘Sick Shelf’ in your medicine cupboard is shipshape and ready, before your hour of need arrives…
OUT WITH THE OLD…
Have a good look at your existing medical supplies – and be ruthless about pitching anything past its ‘best by’ date. Like everything else, drugs have a lifespan. And while most health experts agree that accidentally popping an out-of-date pain pill (or two) will not cause serious harm, they also agree that drugs lose their potency over time.
Once you’ve cleared some space, it’s time to restock. But with what?
TESTING, TESTING
Make sure you have some Covid tests on hand, just in case (we stock individual tests for $6.95). The latest Government guidelines recommend that you stay at home until 24 hours after the fever and symptoms (sore throat, coughing, aches and pains) subside – without help from pain meds. You need to be particularly vigilant if you are going to come into contact with vulnerable groups – seniors, babies under six months, or anyone with a weakened immune system (cancer sufferers, for instance) – or attending an indoor gathering, where you don’t know who you will encounter.
FEVER PITCH…
Do you have a good thermometer in your house? If you still have an old-school mercury model, it’s worth investing in something easier to read – and safer (the consequences of a breakage and subsequent spill are not worth thinking about). An accurate temperature reading will help you tell if you’ve got a cold (which usually does not cause a high fever) and Covid or Flu. Which do. Keeping track of your temperature will also let you know when it’s safe to stop isolating. FYI, a fever is considered to be anything over 100.4 F (or 38 C).
We have a number of different, easy to read digital thermometers available for oral use that are very inexpensive.
OH, THE PAIN
There should be TWO kinds of over-the-counter pain relief on your Sick Shelf. Acetaminophen (Tylenol or Paracetamol), and an NSAID (non-steroidal anti-inflammatory drug) like ibuprofen (Advil or Cuprofen), naproxen (Aleve), or aspirin. Both types tackle aches, pains and fever. But because they work in different ways, you can take them together (or better yet, stagger them): the recommended dose of paracetamol or Tylenol; followed (two hours later) by a similar dose of an NSAID (taken with food, to prevent risk of tummy upset or ulcers).
And remember: if you have children in the house, you will also need pain relief for them. Oral suspensions of paracetamol and ibuprofen are available in store – but ask the pharmacist for advice on what medication would be best for your child.
DON’T BE SNIFFY…
If it’s a cold you’ve got, a saline nasal spray can help to ease congestion. And because it’s all-natural, you don’t have to worry if you are taking other medication – blood pressure pills, for instance, or antidepressants (both of which WILL rule out decongestants, which can elevate your pressure). They are even safe for children (Calpol do a nasal spray and nasal drops which can be used on infants, but again, check with the pharmacist to find your best option).
READY FOR THE COUGH
One particularly annoying symptom of Covid is the cough you just cannot suppress. Not only is it maddening for you – it’s also not going to endear you to those around you. You can try to cough into your elbow, or a hanky, but having a supply of good cough lozenges on hand is another way to go. We stock cough drops by Halls, Ricola and Fisherman’s Friend, to name just three – and sugar-free versions are also usually available.
Stephanie Simons is the head pharmacist at Lindo’s Pharmacy in Devonshire. She earned her Bachelor of Science in Pharmacy at Massachusetts College of Pharmacy and has been practicing for over 20 years. She is a registered pharmacist with the Bermuda Pharmacy Council and is a member of the Bermuda Pharmaceutical Association.
Keep those infections at bay!
Antimicrobial susceptibility tests are used to determine which specific antibiotics a particular bacteria or fungus is sensitive to.

By Stephanie Simons,
Head Pharmacist,
Lindo’s Pharmacy in Devonshire
October 13-19 is International Infection Prevention Week. And at a time when medical experts are becoming more and more concerned about anti-microbial resistance – in layman’s terms, when bacteria and viruses become immune to antibiotics and other drugs – it’s something we should all be paying attention to.
A survey published in medical journal The Lancet last month (September) claimed that from 1990-2021, more than a million people died from drug resistant infections. Every year. The research, carried out by the UK Department of Health and Social Care with the backing of the Wellcome Trust, looked at data from 204 countries and territories. And it went further – predicting that by 2050, another 39 million people around the world could succumb to antibiotic-resistant infections.
The thought of bugs that can’t be beaten by modern drugs is scary. But there are things we can do, while we wait for scientists to discover new antibiotics, to prevent ourselves from getting sick in the first place.
FIRST, WASH YOUR HANDS…
Yes, that old line. But one of the few good things to come out of Covid-19 was the fact that it made us all think, afresh, about the importance of good hygiene. And just because the hysteria has abated, it doesn’t mean we should abandon the healthy habits we learned during the pandemic.
Wash your hands frequently and make the process fun – or at least moderately enjoyable. (Remember: doing it properly requires 20 seconds of lathering and rinsing!) Pitch that cracked, old sliver of soap by the sink and replace it with a bottle of liquid soap like Method’s ‘Sweet Water’ foaming handwash – or a big luxurious bar (check out our Nesti Dante range) – to encourage family and visitors to go to town.
THE FIRST CUT IS THE DEEPEST…
Scientists still don’t understand, completely, how the immune system works. Mainly because It’s a system, not one single thing. But we do know that microbes enter our bodies through openings – our mouths, noses, and a few more you can probably think of. And they can also get in through wounds.
So, when you get a cut or a graze don’t shilly-shally. We have a whole range of disinfectants to treat minor wounds – Bactine Max not only does the job but numbs the pain, too. And if you do yourself a damage while you’re out and about, we have something for that, too. We stock packs of wound cleansing wipes and anti-bacterial hand wipes, so you can be prepared, wherever you are.
GIVE YOUR BODY A BOOST
There is a lot of talk about ways you can improve your immune system with vitamins or herbs or supplements. But bombarding your body with large amounts of a single vitamin or mineral is not a great idea. A healthy diet, involving plenty of fresh fruit and veg – like the ones you see displayed right outside our pharmacy – should give you everything you need, to keep your T-cells (the white blood cells that are the body’s small soldiers) in tip-top shape.
But if you know your diet is deficient in some way – if you hate vegetables, for instance; or find, now that you are older, that your appetite has dwindled – then taking a multi-vitamin can plug the gaps and give your body a helping hand. We have a great selection of multivitamins on offer, for all ages. Chewable (tasty) ones, from Olly, for those who don’t like swallowing pills. And specific ones for your time of life – children, pregnant women, men, seniors – to make sure you are ready to repel whatever germs come your way.
DON’T FORGET TO FLOSS
Remember that bit about places where germs can get in? Well, your mouth is a prime spot for invasion. Which is why oral hygiene is so important. Surveys show that flossing at least once a day (preferably right before you brush!) can help to prevent build-up of bacteria. Which gives your immune system a helping hand. Check out our range of flosses, tapes and flosspicks, in our dental health section.
GRAB A JAB…
Finally, keep up to date with vaccinations! Studies show that for people over 65, respiratory infections – like Flu and Covid-19 – are major killers. So, it’s really important to get those jabs when they are offered. Although we don’t offer vaccinations at our pharmacy, the Government does run a Flu Express program every autumn (dates announced soon on the Government website, gov.bm) under which seniors (65 and over) can get protected for free. Everyone else is $20 – a small price to pay for peace of mind. If you miss the Express, talk to your doctor, or call the Hamilton Health Centre on 278-6460 or 278-6461 to book an appointment.
Stephanie Simons is the head pharmacist at Lindo’s Pharmacy in Devonshire. She earned her Bachelor of Science in Pharmacy at Massachusetts College of Pharmacy and has been practicing for over 20 years. She is a registered pharmacist with the Bermuda Pharmacy Council and is a member of the Bermuda Pharmaceutical Association.
September is Alzheimer’s Awareness Month

By Stephanie Simons,
Head Pharmacist,
Lindo’s Pharmacy in Devonshire
September is Alzheimer’s Awareness Month in Bermuda and around the world. And these days, who isn’t aware of Alzheimer’s, and dementia in general?
In a tight-knit community like Bermuda, we all know someone who is a victim – personally. A friend, a neighbour, a family member. We also know the effect it can have on sufferers, and those who love and care for them.
Alzheimer’s is the most common kind of dementia (an umbrella term which covers a number of progressive diseases that affect memory, thinking and behaviour), afflicting more than half of all sufferers. Last year, dementia – including Alzheimer’s – was the single biggest cause of death in the UK. Here on the Island, local dementia experts NorthStar reckon that as many as 3,000 people may be living with dementia – most of them cared for by their families.
For some reason, which scientists still don’t understand, women are twice as likely to get it as men. The biggest contributing factor is age – and obviously we can’t stop the clock.
There is also evidence that some of us may be more genetically disposed to getting it – particularly the early onset varieties. And again, we can’t (yet) change our genes.
But there ARE some things we can do, to help us ward off the onset of this terrible disease, while research scientists – who are making progress all the time – come up with better drugs to slow its progress and, eventually, find a cure.
Exercise
Physical activity is not just good for your body, and your soul – there are signs that regular exercise may help to stave off the onset of dementia. It also helps to combat obesity (another trigger for dementia) as well as depression (ditto). Studies show that two and a half hours of moderate exercise, spread out over a week, can make a difference. Take a walk on the beach or along the railway trail. Do some energetic gardening. Or book a dance class – learning new steps will boost your fitness AND improve your memory.
Stop smoking
We know that smoking is bad for your lungs – but it may be bad for your brain, too. A 2019 survey found that smokers were 40 per cent more likely to develop Alzheimer’s than those who’d never lit up. If you’ve quit…dozens of times… and it just doesn’t stick, why not check out some of the remedies we have on offer? Nicotine Replacement Therapy treatments are available in many forms – including skin patches (Nicotinell), chewing gum and lozenges (Nicorette). Talk to one of our pharmacists if you are serious about kicking the habit.
Take a Vitamin D supplement
A deficiency of Vitamin D has been linked to increased likelihood of getting Alzheimer’s. Luckily, in Bermuda, most of us get enough of ‘the sunshine vitamin’ straight from source. But some people – older folks, and anyone with kidney or liver problems – may have lower levels. We stock a number of daily Vitamin D supplements, in pill, gummy and drops form, such as Sun Warrior Vitamin D3 and Now and Nature’s Truth brands for those who need a boost.
Look after your teeth and gums!
It may sound crazy, but medical studies have shown a link between gum disease and Alzheimer’s. The bacteria that cause periodontal disease can travel to, and affect, your brain. We have a whole range of products that can help keep your gums in the pink – ranging from traditional dental floss and wax to flossing sticks, interdental brushes and electric water picks. We also stock Gum Stimulators – rubber-tipped gadgets you can use to gently massage your gums.
If you want to learn more about Alzheimer’s, or suspect that someone you know and love may be affected, why not visit Action on Alzheimer’s and Dementia (aad.bm), their affiliates Alzheimer’s Disease International (alzint.org), and NorthStar Dementia (northstardementia.bm).
Stephanie Simons is the head pharmacist at Lindo’s Pharmacy in Devonshire. She earned her Bachelor of Science in Pharmacy at Massachusetts College of Pharmacy and has been practicing for over 20 years. She is a registered pharmacist with the Bermuda Pharmacy Council and is a member of the Bermuda Pharmaceutical Association.













